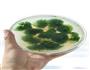
蔬菜水晶冻的做法图解13

| 蔬菜水晶冻热量分析 (可根据实际输入食材份量计算。数据仅供参考) | |||||
|---|---|---|---|---|---|
| 食材名称 | 食材份量 | 热量 | 标准度量(每100克) | 蛋白质 | 脂肪 |
| 猪皮 | 克 | 1436千卡 | 385千卡 | 27.4克 | 28.1克 |
| 总量 | 373克 | 蔬菜水晶冻热量/卡路里1436千卡 | |||
蔬菜水晶冻的做法共16个步骤
食材主料/辅料
猪皮(适量)、西兰花(适量)、精盐(适量)、生姜(适量)、大蒜(适量)、味极鲜酱油(适量)、香油(适量)

1/16. 猪皮入煮锅,水开后煮10分钟。

2/16. 捞出煮好的猪皮,晾凉后用刀刮净内侧的油脂。这样做出的肉冻透明剔透。

3/16. 刮净油脂的猪皮,用刀切成细条。

4/16. 锅里坐水,把猪皮条放在锅里大火煮开(主要是去掉猪皮上的残余油脂)。

5/16. 煮锅里重新加清水,把猪皮条倒入锅里,放入生姜。

6/16. 大火煮开后用小火煮1小时。

7/16. 调入精盐,关火。

8/16. 煮好的猪皮汤凉后盛到准备好的容器里,约占容器的1/4。(分多次盛入,可以让猪皮在肉冻里均匀不沉底),把盛好的容器放在窗台上,自然冷冻。

9/16. 西兰花洗净焯水,捞出控净水。

10/16. 再次舀猪皮汤到先前的容器里。

11/16. 等猪皮汤稍微凝固成肉冻,把西兰花按入肉冻里。

12/16. 再浇上热的猪皮汤,漫过西兰花,盖好容器的盖子,放在阴冷的地方自然冷冻。
13/16. 冷冻数小时即可成弹性很足的肉冻,肉冻切成大片,蘸料汁食用。

14/16. 蒜瓣用蒜臼子捣成泥,调入味极鲜酱油,少许精盐。

15/16. 滴入香油拌匀。

16/16. 皮冻用刀切成厚片,浇上蒜泥味汁。
食材功效信息
猪皮的热量385千卡(每100克);有利含量:低钠盐,低饱和脂肪酸,富含维生素B12,富含蛋白质;不利含量:胆固醇含量过高;具有减少皱纹、延缓衰老、活血止血等功效;
你可能还喜欢
营养信息
- 蔬菜水晶冻热量1436 千卡
- 脂肪28.1 克
- 蛋白质27.4 克
- 碳水化合物0 克
- 钠0 毫克
- 钙0 毫克
- 铁0 毫克
- 钾0 毫克










